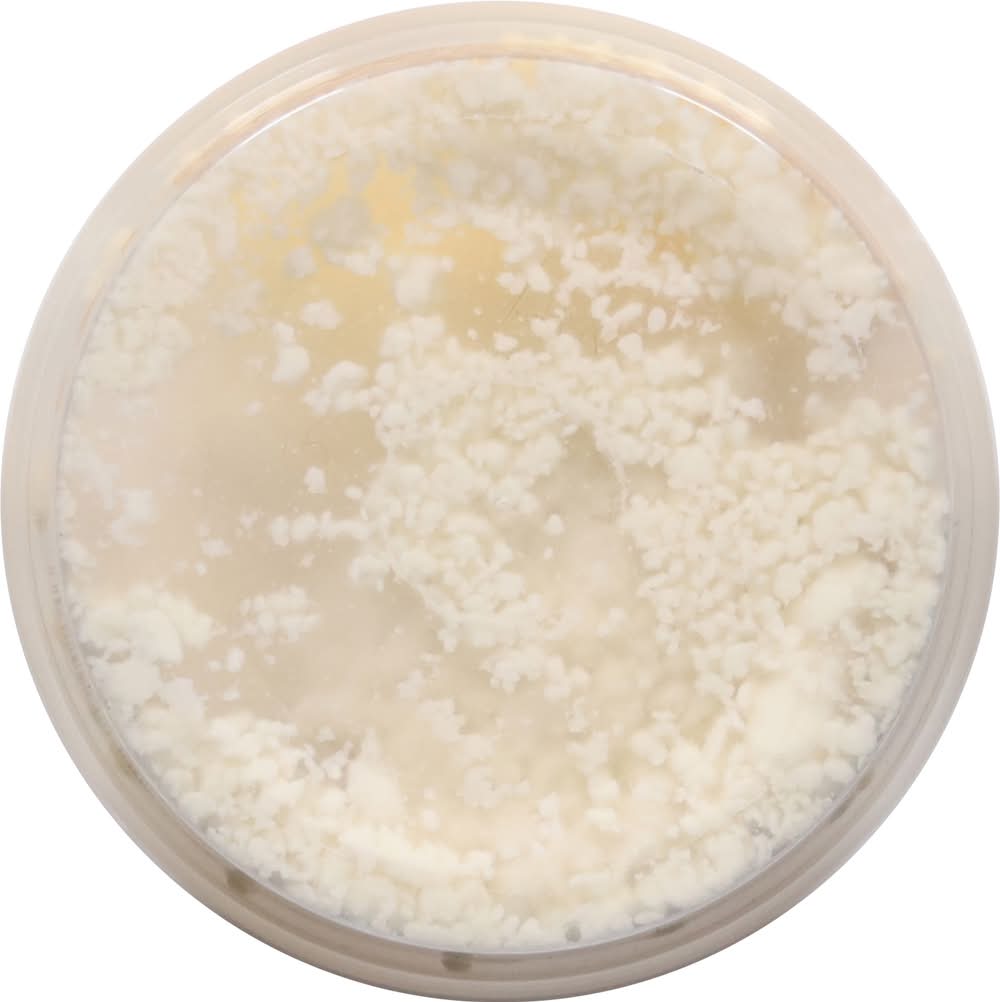

Fresh Thyme Market
4.9
(100+ ratings)
x No delivery people nearby 2850 E. Centre Dr, Beavercreek, OH 45324
LaClare Creamery Crumbled Honey Goat Cheese (4 oz)
$5.48
4 oz
Details
Goat Cheese, Honey, Crumbled
Show more
Ingredients
Ingredients: Whole Pasteurized Goat Milk, Salt, Honey Granules (Cane Sugar, Honey), Cheese Cultures, Enzymes, Cellulose (Anti-Caking) Contains: Milk
Show more
Nutrition Facts
The information shown here may not be current, complete, or accurate. Always check the item's packaging for product information and warnings.